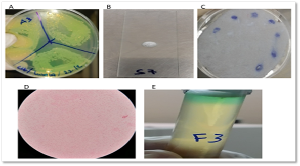

Recovered from Disinfectants Often Used in Khartoum Tertiary Care Hospitals, Pseudomonas Aeruginosa Isolates are able to Produce β-lactamase Resistance Enzymes
Authors
##plugins.themes.bootstrap3.article.main##
Abstract
Background and study aim: Disinfectants play a crucial role in infection control in hospitals, but some bacteria can resist these disinfectants or contaminate them. This study aims to investigate the potential disinfectant contamination in Sudanese hospitals by Pseudomonas Aeruginosa (P. aeruginosa). Methods: The study period for this cross-sectional investigation was between November 2020 and October 2021. The actual collection of disinfectant samples was over a three-week period within that timeframe. Analysis was conducted on 44 disinfectant samples from nine hospitals in Khartoum state. The 44 disinfectant samples collected encompassed 9 distinct types of disinfectants commonly used in hospital settings. The presence of P. aeruginosa was determined using a combination of microbiological methods and genotypic techniques based on Polymerase Chain Reaction (PCR). The antibiotic susceptibility of bacterial isolates was assessed using the disc diffusion method. Additionally, PCR was used to identify a number of ß-lactamase genes. Results: Among 44 disinfectant samples, 7 samples (15.9%) tested positive for P. aeruginosa contamination. Contamination was most frequently observed in chloroxylenol-based disinfectants (5/9), followed by sodium hypochlorite (1/6) and chlorhexidine gluconate–cetrimide formulations (1/1). P. aeruginosa showed resistance to both the cephalosporin and penicillin groups of antibiotics, and all isolates tested positive for the blaTEM-1 resistance gene. Conclusions: Significant contamination with P. aeruginosa was found in the disinfectant samples examined, posing a risk to hospital patients.
##plugins.themes.bootstrap3.article.details##
Copyright (c) 2025 Lubaba S. Eisa, MSc, Rehab Ahmed, PhD

This work is licensed under a Creative Commons Attribution 4.0 International License.
Creative Commons License All articles published in Annals of Medicine and Medical Sciences are licensed under a Creative Commons Attribution 4.0 International License.
Lubaba S. Eisa, MSc, Pharmaceutical Biotechnology Master Program, Department of Pharmaceutics, Faculty of Pharmacy, University of Khartoum, Khartoum 11111, Sudan.
Pharmaceutical Biotechnology Master Program, Department of Pharmaceutics, Faculty of Pharmacy, University of Khartoum, Khartoum 11111, Sudan.
Rehab Ahmed, PhD, Department of Pharmaceutics, Faculty of Pharmacy, University of Khartoum, Khartoum, Sudan.
Department of Pharmaceutics, Faculty of Pharmacy, University of Khartoum, Khartoum, Sudan.
[1] Mohapatra S. Sterilization and Disinfection. Essentials of Neuroanesthesia 2017; 929–944. DOI:10.1016/B978-0-12-805299-0.00059-2
[2] Tapouk FA, Nabizadeh R, Mirzaei N, Jazani NH, Yousefi M. Comparative efficacy of hospital disinfectants against nosocomial pathogens. Antimicrobial Resistance & Infection Control 2020; 9: 1–7. DOI: 10.1186/s13756-020-00781-y
[3] Suleyman G, Alangaden G, Bardossy AC. The role of environmental contamination in the transmission of nosocomial pathogens and healthcare-associated infections. Current infectious disease reports 2018; 20: 12. DOI: 10.1007/s11908-018-0620-2
[4] Keah KC, Jegathesan M, Tan SC, Chan SH, Chee OM, Cheong YM, et al. Bacterial contamination of hospital disinfectants. Med J Malaysia 1995; 50: 291-297.
[5] Van Dijk H, Verbrugh HA. Resisting disinfectants. Communications medicine 2022; 2: 6. DOI: 10.1038/s43856-021-00070-8
[6] Reynolds D, Kollef M. The epidemiology and pathogenesis and treatment of Pseudomonas Aeruginosa infections: an update. Drugs 2021; 81: 2117–2131. DOI: 10.1007/s40265-021-01635-6
[7] Pottier M, Gravey F, Castagnet S, Auzou M, Langlois B, Guérin F, et al. A 10-year microbiological study of Pseudomonas Aeruginosa strains revealed the circulation of populations resistant to both carbapenems and quaternary ammonium compounds. Scientific Reports 2023; 13: 26–39. DOI: 10.1038/s41598-023-29590-0
[8] Bakht M, Alizadeh SA, Rahimi S, Anari RK, Rostamani M, Javadi A, et al. Phenotype and genetic determination of resistance to common disinfectants among biofilm-producing and non-producing Pseudomonas Aeruginosa strains from clinical specimens in Iran. BMC microbiology 2022; 22: 124. DOI: 10.1186/s12866-022-02524-y
[9] Elabed H, González-Tortuero E, Ibacache-Quiroga C, Bakhrouf A, Johnston P, Gaddour K, Blázquez J, Rodríguez-Rojas A. Seawater salt-trapped Pseudomonas Aeruginosa survives for years and gets primed for salinity tolerance. BMC microbiology 2019; 19:142. DOI: 10.1186/s12866-019-1499-2
[10] Wang C, Shang Y, Li F. Pseudomonas Aeruginosa detection using conventional PCR and quantitative real-time PCR based on species-specific novel gene targets identified by pangenome analysis. Frontiers in Microbiology 2022; 13: 820431. DOI: 10.3389/fmicb.2022.820431
[11] Babour IA, Mohamed MB, Shehabi AA. Molecular characterization of Pseudomonas Aeruginosa isolates from various clinical specimens in Khartoum/Sudan: Antimicrobial resistance and virulence genes. The International Arabic Journal of Antimicrobial Agents 2020; 10: 10–3823. DOI: 10.12691/ajidm-11-1-1
[12] Tang Y, Ali Z, Zou J, Jin G, Zhu J, Yang J, et al. Detection methods for Pseudomonas Aeruginosa: history and future perspective. Rsc Advances 2020; 82: 51789–51800. DOI: 10.1039/C7RA09064A
[13] Ullah W, Qasim M, Rahman H, Jie Y, Muhammad N. Beta-lactamase-producing Pseudomonas Aeruginosa: Phenotypic characteristics and molecular identification of virulence genes. Journal of the Chinese Medical Association 2017; 80: 173–177. DOI: 10.1016/j.jcma.2016.08.011
[14] Al-Ahmadi GJ, Roodsari RZ. Fast and specific detection of Pseudomonas Aeruginosa from other pseudomonas species by PCR. Annals of burns and fire disasters 2016; 29: 264–267.
[15] Dehbashi S, Tahmasebi H, Alikhani MY. Distribution of Class B and Class A β-lactamases in clinical strains of Pseudomonas Aeruginosa: comparison of phenotypic methods and high-resolution melting analysis (HRMA) assay. Infection and Drug Resistance 2020; 2037–2052. DOI: 10.2147/IDR.S255292
[16] Castanheira M, Simner PJ, Bradford PA. Extended-spectrum β-lactamases: An update on their characteristics, epidemiology and detection. JAC-antimicrobial resistance2021; 3: dlab092. DOI: 10.1093/jacamr/dlab092
[17] Zhao W, Hu Z. β-Lactamases identified in clinical isolates of Pseudomonas Aeruginosa. Critical reviews in microbiology 2021; 36: 245–258. DOI: 10.3109/1040841X.2010.481763
[18] Bush K, Bradford PA. β-Lactams and β-lactamase inhibitors: an overview. Cold Spring Harbor perspectives in medicine 2016; 6: a025246. DOI: 10.1101/cshperspect.a025247
[19] Sawa T, Kooguchi K, Moriyama K. Molecular diversity of extended-spectrum β-lactamases and carbapenemases, and antimicrobial resistance. Journal of intensive care 2020; 8: 1–3. DOI: 10.1186/s40560-020-0429-6
[20] Glen KA, Lamont IL. β-lactam resistance in Pseudomonas Aeruginosa: Current status, future prospects. Pathogens 2021; 10: 1638. DOI: 10.3390/pathogens10121638
[21] Sedighi M, Halajzadeh M, Ramazanzadeh R, Amirmozafari N, Heidary M, Pirouzi S. Molecular detection of β-lactamase and integron genes in clinical strains of Klebsiella pneumoniae by multiplex polymerase chain reaction. Revista da Sociedade Brasileira de Medicina Tropical 2017; 50: 321–328. DOI: 10.1590/0037-8682-0001-2017
[22] Shah AA, Hasan F, Ahmed S, Hameed A. Characteristics, epidemiology and clinical importance of emerging strains of Gram-negative bacilli producing extended-spectrum β-lactamases. Research in microbiology 2004; 155: 409–421. DOI: 10.1016/j.resmic.2004.02.009
[23] Evans BA, Amyes SG. OXA β-Lactamases. Clinical microbiology review 2014; 27: 241–263. DOI: 10.1128/CMR.00117-13.
[24] Dimri AG, Chaudhary S, Singh D, Chauhan A, Aggarwal M. Morphological and biochemical characterization of food borne gram-positive and gram-negative bacteria. Science Archives 2020;1 :16-23. DOI: 10.1099/mic.0.000027
[25] Mama M, Abdissa A, Sewunet T. Antimicrobial susceptibility pattern of bacterial isolates from wound infection and their sensitivity to alternative topical agents at Jimma University Specialized Hospital, South-West Ethiopia. Annals of clinical microbiology and antimicrobials 2014; 13: 1–10. DOI: 10.1186/1476-0711-13-14
[26] Junior R, Carlos J, Soares F, De M, Carlos J, Junior R, et al. Efficiency of boiling and four other methods for genomic DNA extraction of deteriorating spore-forming bacteria from milk. Semina: Ciências Agrárias 2016; 37: 3069–3078. DOI: 10.5433/1679-0359.2016v37n5p3069
[27] Lee P, Costumbrado J, Hsu C, Kim Y. Agarose gel electrophoresis for the separation of DNA fragments. Journal of visualized experiments 2012; 20: 3923. DOI: 10.3791/3923
[28] Abdelrahman DN, Taha AA, Dafaallah MM, Mohammed AA, El Hussein AR.M, Hashim AI. et al. β-lactamases (bla TEM, bla SHV, bla CTXM-1, bla VEB, bla OXA-1) and class C β-lactamases gene frequency in Pseudomonas Aeruginosa isolated from various clinical specimens in Khartoum State, Sudan: A cross sectional study. F1000Research 2020; 9: 1–16. DOI: 10.12688/f1000research.2 4818.3
[29] Lompo P, Heroes AS, Agbobli E, Kazienga A, Peeters M, Tinto,H. et al. Growth of Gram-Negative Bacteria in Antiseptics, Disinfectants and Hand Hygiene Products in Two Tertiary Care Hospitals in West Africa—A Cross-Sectional Survey. Pathogens 2023; 12: 917. DOI: 10.3390/pathogens12070917.
[30] Misra RN. Resistance of Pseudomonas Aeruginosa to Disinfectants. Medical Journal of Dr. DY Patil Vidyapeeth 2021; 14:51. DOI: 10.4103/mjdrdypu.mjdrdypu_626_20
[31] Gajadhar T, Lara A, Sealy P, Adesiyun AA. Microbial contamination of disinfectants and antiseptics in four major hospitals in Trinidad. Rev Panam Salud Publica/Pan Am J Public Heal 2003; 14: 193–200. DOI: 10.1590/s1020-49892003000800006
[32] Christensen EA, Jepsen OB, Kristensen H. Steen G. In-use tests of disinfectants. Acta Pathologica Microbiologica Scandinavica Series B: Microbiology 1982; 90: 95–100. DOI: 10.1111/j.1699-0463.1982.tb00088.x.
[33] West AM, Teska PJ, Lineback CB, Oliver HF. Strain, disinfectant, concentration, and contact time quantitatively impact disinfectant efficacy. Antimicrobial Resistance & Infection Control 2018; 7: 1–8. DOI: 10.1186/s13756-018-0340-2.
[34] Rozman U, Pušnik M, Kmetec S, Duh D, Turk SŠ. Reduced susceptibility and increased resistance of bacteria against disinfectants: A systematic review. Microorganisms 2021; 9: 2550. DOI: 10.3390/microorganisms9122550
[35] Mapipa Q, Digban TO, Nnolim NE, Nwodo UU. Antibiogram profile and virulence signatures of Pseudomonas Aeruginosa isolates recovered from selected agrestic hospital effluents. Scientific Reports 2021; 11: 11800. DOI: 10.1038/s41598-021-91280-6.
[36] Douraghi, M, Ghasemi F, Soltan Dallal MM, Rahbar M, Rahimiforoushani A. Molecular identification of Pseudomonas Aeruginosa recovered from cystic fibrosis patients. J Prev Med Hyg 2014; 55(2) 50–53. DOI: 10.30574/gscbps.2023.24.2.0335
[37] Hassan KI, Rafik SA, Mussum K. Molecular identification of Pseudomonas Aeruginosa isolated from Hospitals in Kurdistan region. J Adv Med Res 2012; 2: 90–98.
[38] Abdullahi R, Lihan S, Carlos BS, Bilung ML, Mikal MK, Collick F. Detection of oprL gene and antibiotic resistance of Pseudomonas Aeruginosa from aquaculture environment. European Journal of Experimental Biology 2013; 3: 148–152.
[39] Rafailidis PI, Kofteridis D. Proposed amendments regarding the definitions of multidrug-resistant and extensively drug-resistant bacteria. Expert Review of Anti-infective Therapy 2021; 20: 139–146. DOI: 10.1080/14787210.2021.1945922.
[40] Li L, Ge H, Gu D, Meng H, Li Y, Jia M. The role of two-component regulatory system in β-lactam antibiotics resistance. Microbiological research 2018; 215: 126–129. DOI: 10.1016/j.micres.2018.07.005.